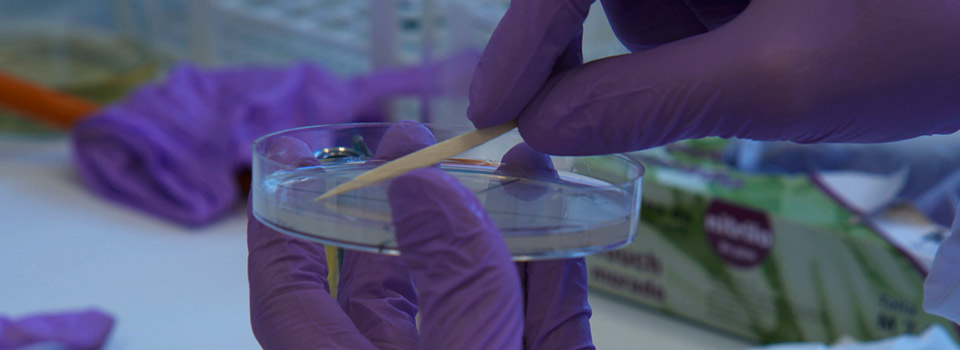
Bacterias para plantas

TESIS
Tesis es un programa de televisión producido por CEDECOM que se emite en Canal Sur. Esta enfocado principalmente a la difusión y divulgación de las actividades culturales, académicas y de investigación que se llevan a cabo en la Universidad Pública de Andalucía. El programa de TV, Tesis cubre, a través de reportajes, entrevistas y noticias, la información, los eventos y los contenidos de las distintas fuentes de conocimiento, proyectando los temas de interés social de los que se ocupa la Universidad de Andalucía.
Próximamente…
IMMa-EV: EL VEHÍCULO ELÉCTRICO QUE TRANSFORMA LA CARRETERA EN UN LABORATORIOCedecomProduccion-Audiovisual2025-11-21T19:27:58+01:00
JOYERÍA CORDOBESA: DONDE LA TRADICIÓN SE FUNDE CON LA INNOVACIÓNCedecomProduccion-Audiovisual2025-11-15T19:33:38+01:00
DOLMEN DE TEBA: UN VIAJE AL MEGALITISMO EN ANDALUCÍACedecomProduccion-Audiovisual2025-11-14T22:01:49+01:00
EL JUEGO DEL TERCER RICINO: ARTE, RITUAL Y REFUGIO EN LA OBRA DE ANA MORALESCedecomProduccion-Audiovisual2025-11-07T19:16:32+01:00
VANTUS: EL SUEÑO UNIVERSITARIO QUE DESPEGA DESDE SEVILLACedecomProduccion-Audiovisual2025-11-07T18:47:53+01:00
PREMIOS SPIN-OFF: TALENTO, INNOVACIÓN Y EMPRENDIMIENTO UNIVERSITARIOCedecomProduccion-Audiovisual2025-11-01T13:56:37+01:00
MUSEO DE GEOLOGÍA DE SEVILLA: UN MUSEO PARA LA MEMORIA GEOLÓGICACedecomProduccion-Audiovisual2025-11-01T13:33:37+01:00
UNIVERSIDAD CONTRA EL FUEGO: CIENCIA Y PREVENCIÓN PARA SALVAR LOS BOSQUESCedecomProduccion-Audiovisual2025-10-31T18:46:14+01:00
NATURALEZAS ENTRÓPICAS: CUANDO EL ARTE RECONSTRUYE LA MEMORIACedecomProduccion-Audiovisual2025-10-25T14:28:53+02:00
IMPACTO ECONÓMICO Y EMOCIONAL DE LA INDUSTRIA DEL FÚTBOLCedecomProduccion-Audiovisual2025-10-25T12:49:52+02:00
ENERGÍA INTELIGENTE: EL FUTURO DE LAS MÁQUINAS MULTIFÁSICASCedecomProduccion-Audiovisual2025-10-24T16:58:52+02:00
DEL UNIVERSO AL OÍDO: ESCUCHANDO EL CANTE DE LAS ESTRELLASCedecomProduccion-Audiovisual2025-10-18T13:58:35+02:00
ZARZUELA: DEL ESCENARIO AL AULA, UNA LECCIÓN DE CULTURA Y MÚSICACedecomProduccion-Audiovisual2025-10-18T12:49:34+02:00
MARILU GUTIÉRREZ: UNA VIDA DETRÁS DE LAS CÁMARASCedecomProduccion-Audiovisual2025-10-17T19:34:56+02:00
CUANDO LAS CÁMARAS PIENSAN: VIDEOVIGILANCIA INTELIGENTECedecomProduccion-Audiovisual2025-10-17T17:36:37+02:00
COMIC-CON MÁLAGA: EL UNIVERSO POP LLEGA A ESPAÑACedecomProduccion-Audiovisual2025-10-11T13:38:27+02:00
MAMUTS: DESCUBRIENDO LOS ORÍGENES DEL PRIMER VIAJE HUMANOCedecomProduccion-Audiovisual2025-10-11T12:54:44+02:00
OCEANARIA: INTELIGENCIA ARTIFICIAL PARA DISFRUTAR Y PROTEGER LAS PLAYAS DE ANDALUCÍACedecomProduccion-Audiovisual2025-10-04T13:06:50+02:00
OSUNA: EL RENACER ARQUEOLÓGICO QUE REESCRIBE LA HISTORIA DE ANDALUCÍACedecomProduccion-Audiovisual2025-10-03T19:34:46+02:00
EL VIAJE DEL CONOCIMIENTO: SEVILLA Y EL MUNDO DE LAS MARAVILLASCedecomProduccion-Audiovisual2025-06-21T10:53:08+02:00
JOSÉ LUIS PUCHE: EL DIBUJO COMO LENGUAJE UNIVERSALCedecomProduccion-Audiovisual2025-08-01T11:53:29+02:00
HELLO! MY NAME IS PLETÓRICA: LA MIRADA PROVOCADORA DE CARMEN OCAÑACedecomProduccion-Audiovisual2025-06-07T12:16:49+02:00
RED DE UNIVERSIDADES EMPRENDEDORAS: INNOVACIÓN Y EMPLEO DESDE LA UNIVERSIDADCedecomProduccion-Audiovisual2025-05-16T22:53:06+02:00
DESTINO UMA: UN ADELANTO UNIVERSITARIO PARA FUTUROS ESTUDIANTESCedecomProduccion-Audiovisual2025-04-12T02:10:29+02:00
EL MAGMA QUE REVELA LOS SECRETOS DE LOS VOLCANESCedecomProduccion-Audiovisual2025-04-12T02:33:15+02:00
INVESTIGANDO EL SÍNDROME DE QUILOMICRONEMIA FAMILIARCedecomProduccion-Audiovisual2025-04-11T20:11:43+02:00
AYUNO INTERMITENTE: UNA HERRAMIENTA CONTRA LA OBESIDADCedecomProduccion-Audiovisual2025-04-05T13:02:35+02:00
FATIMAH HOSSAINI: MOSAICO DE COLORES EN OJOS QUE CALLANCedecomProduccion-Audiovisual2025-04-05T12:02:09+02:00
PAULA CORONAS: EL TRIUNFO DE LA MÚSICA ESPAÑOLACedecomProduccion-Audiovisual2025-04-04T20:29:03+02:00
LUPUS: LA ENFERMEDAD INVISIBLE QUE ATACA AL CUERPOCedecomProduccion-Audiovisual2025-03-15T12:40:38+01:00
JUVENTUD Y REDES SOCIALES: LA GENERACIÓN DE LAS CABEZAS AGACHADASCedecomProduccion-Audiovisual2025-03-14T19:56:04+01:00
AGROCONNECT: AGRICULTURA INTELIGENTE, SOSTENIBLE Y CONECTADACedecomProduccion-Audiovisual2025-02-24T18:08:10+01:00
6G: LA NUEVA ERA DE LAS COMUNICACIONES YA ESTÁ AQUÍCedecomProduccion-Audiovisual2025-02-24T18:09:44+01:00
NUEVAS TITULACIONES: LA UNIVERSIDAD PÚBLICA ANDALUZA CRECECedecomProduccion-Audiovisual2025-02-08T01:33:48+01:00
ENCUENTRO CON LAS CUEVAS PREHISTÓRICAS DE MÁLAGACedecomProduccion-Audiovisual2025-01-31T19:26:54+01:00
UNA MIRADA ARTÍSTICA AL DAÑO CEREBRAL ADQUIRIDOCedecomProduccion-Audiovisual2025-01-04T11:43:58+01:00
FUERZA Y MÚSCULO, ALIADOS DE LA SALUD FEMENINACedecomProduccion-Audiovisual2024-11-16T12:48:05+01:00
BIOHIDRÓGENO: UNA COMBINACIÓN GANADORA DE ALGAS Y BACTERIASCedecomProduccion-Audiovisual2024-11-16T02:39:35+01:00
INNOVACIÓN FOTOVOLTAICA: CÉLULAS SOLARES DE NANOHILOSCedecomProduccion-Audiovisual2024-11-15T20:19:38+01:00
HIDRÓGENO RENOVABLE PARA LA AVIACIÓN SOSTENIBLECedecomProduccion-Audiovisual2024-11-09T00:41:32+01:00
8 CUMBRES PARA CONCIENCIAR SOBRE TRABAJO SOCIALCedecomProduccion-Audiovisual2024-11-01T12:28:10+01:00
MÁLAGA PARADISE, UNA REFLEXIÓN SOBRE LA CIUDADCedecomProduccion-Audiovisual2024-10-26T00:27:06+02:00
SOLEDAD NO DESEADA: CUANDO ESTAR SOLO NO ES UNA DECISIÓNCedecomProduccion-Audiovisual2024-10-11T21:56:09+02:00
ISAÍAS LAFUENTE: UNIVERSIDAD PÚBLICA, GARANTÍA DE DEMOCRACIACedecomProduccion-Audiovisual2024-10-11T19:40:01+02:00
ARUN MANSUKHANI: CLAVES PARA LAS RELACIONES SANASCedecomProduccion-Audiovisual2024-10-05T12:46:10+02:00
PREVANS: APP PARA PREVENIR Y CONTROLAR LA ANSIEDADCedecomProduccion-Audiovisual2024-10-05T12:46:40+02:00
DESPEGUE: REDUCCIÓN DEL VÓRTICE DE PUNTA DE ALACedecomProduccion-Audiovisual2024-05-31T17:34:58+02:00
DIEGO DELAS: ARTISTA, ARQUITECTO E INVESTIGADORCedecomProduccion-Audiovisual2024-05-17T19:57:13+02:00
TECNOSOCIAL: INNOVACIÓN Y TECNOLOGÍA EN SERVICIOS SOCIALESCedecomProduccion-Audiovisual2024-04-20T13:26:42+02:00
SUSANA GUERRERO: LENGUAJE QUE HABLA DE IGUALDADCedecomProduccion-Audiovisual2024-03-08T22:06:51+01:00
MARÍA JOSÉ DE LA TORRE: ROYAL HISTORICAL SOCIETYCedecomProduccion-Audiovisual2024-02-10T12:23:29+01:00
INTELIGENCIA ARTIFICIAL PARA LA SEGURIDAD VIALCedecomProduccion-Audiovisual2024-01-19T20:12:23+01:00
MUJERES Y EDUCACIÓN: ARTEFACTOS Y SENSIBILIDADESCedecomProduccion-Audiovisual2024-01-13T01:01:15+01:00
BIOPLÁSTICOS DE DESECHOS DE AGUACATES Y CRUSTÁCEOSCedecomProduccion-Audiovisual2024-01-12T19:09:43+01:00
IATUR: INSTITUTO ANDALUZ DE INVESTIGACIÓN E INNOVACIÓN EN TURISMOCedecomProduccion-Audiovisual2023-12-29T19:49:49+01:00
BANCO DE DATOS PARA LA PREVENCIÓN DEL SUICIDIOCedecomProduccion-Audiovisual2023-12-15T23:23:43+01:00
BIOGEOGRAFÍA CONTRA EL VIRUS DEL NILO OCCIDENTALCedecomProduccion-Audiovisual2023-12-15T23:19:29+01:00
CEMEDE: UN CENTRO MÉDICO PARA CABALLOS DE DEPORTECedecomProduccion-Audiovisual2023-12-01T22:40:55+01:00
ALEJANDRO TIANA FERRER, IMPULSANDO LA EDUCACIÓN EN ESPAÑACedecomProduccion-Audiovisual2023-11-18T00:22:55+01:00
CENTRO DE GESTIÓN Y RESTAURACIÓN DEL PATRIMONIOCedecomProduccion-Audiovisual2023-11-10T19:18:37+01:00
SECRETOS ENTERRADOS: EXCAVACIÓN CERRO DEL VILLARCedecomProduccion-Audiovisual2023-11-04T00:13:55+01:00
CAMPEONATO UNIVERSITARIO EUROPEO DE DEPORTES PLAYA EN MÁLAGACedecomProduccion-Audiovisual2023-10-27T20:01:34+02:00
PREMIOS SPIN-OFF UMA: INNOVACIÓN Y EMPRENDIMIENTOCedecomProduccion-Audiovisual2023-10-20T22:29:18+02:00
GREENCITIES Y S-MOVING: INNOVACIÓN Y SOSTENIBILIDAD URBANACedecomProduccion-Audiovisual2023-10-20T19:56:18+02:00
AURORA LUQUE: LA POETA DE LA EXPERIENCIA PRESENTECedecomProduccion-Audiovisual2023-10-07T11:25:30+02:00
FESTIVAL VERDIAL: FIESTA DE LAS LETRAS Y LA CULTURACedecomProduccion-Audiovisual2023-06-24T01:14:30+02:00
EGIPTO: ARQUITECTURA Y PAISAJE EN TORNO AL SOLCedecomProduccion-Audiovisual2023-01-21T00:25:41+01:00
MINERÍA Y DESARROLLO: LA TIERRA DE LOS METALESCedecomProduccion-Audiovisual2022-12-16T14:46:34+01:00
ROCAS Y MICROCONTINENTES, ÉRASE UNA VEZ LA TIERRACedecomProduccion-Audiovisual2022-06-25T13:31:26+02:00
PERVERSIONES DE LA SIMETRÍA, INSPIRACIÓN LINEALCedecomProduccion-Audiovisual2022-06-25T12:41:08+02:00
VIAJAEROS ROMÁNTICOS: LOS ORÍGENES DEL TURISMOCedecomProduccion-Audiovisual2022-05-28T12:26:09+02:00
INTELIGENCIA ARTIFICIAL VS FAKE NEWS Y CIBERBULLYINGCedecomProduccion-Audiovisual2022-05-14T13:29:45+02:00
CIBERVIOLENCIA DE GÉNERO, DISCRIMINACIÓN TECNOLÓGICACedecomProduccion-Audiovisual2022-05-06T13:22:29+02:00
INNOVACIÓN Y TECNOLOGÍA PARA LOS SERVICIOS SOCIALESCedecomProduccion-Audiovisual2022-04-23T12:34:05+02:00
CUIDADO DE LA SALUD FÍSICA Y MENTAL, UMA SALUDABLECedecomProduccion-Audiovisual2022-04-22T12:36:31+02:00
IÑAKI HORMAZA, DESDE EL CORAZÓN DE LAS PLANTASCedecomProduccion-Audiovisual2022-04-15T12:57:28+02:00
DERECHO DE SOCIEDADES: REGULANDO LA VOLUNTAD EMPRESARIALCedecomProduccion-Audiovisual2022-03-05T14:19:38+01:00
MARGA SÁNCHEZ: EL LADO FEMENINO DE LA HISTORIACedecomProduccion-Audiovisual2025-02-24T12:55:54+01:00
REPORTAJES DEL PROGRAMA TESIS